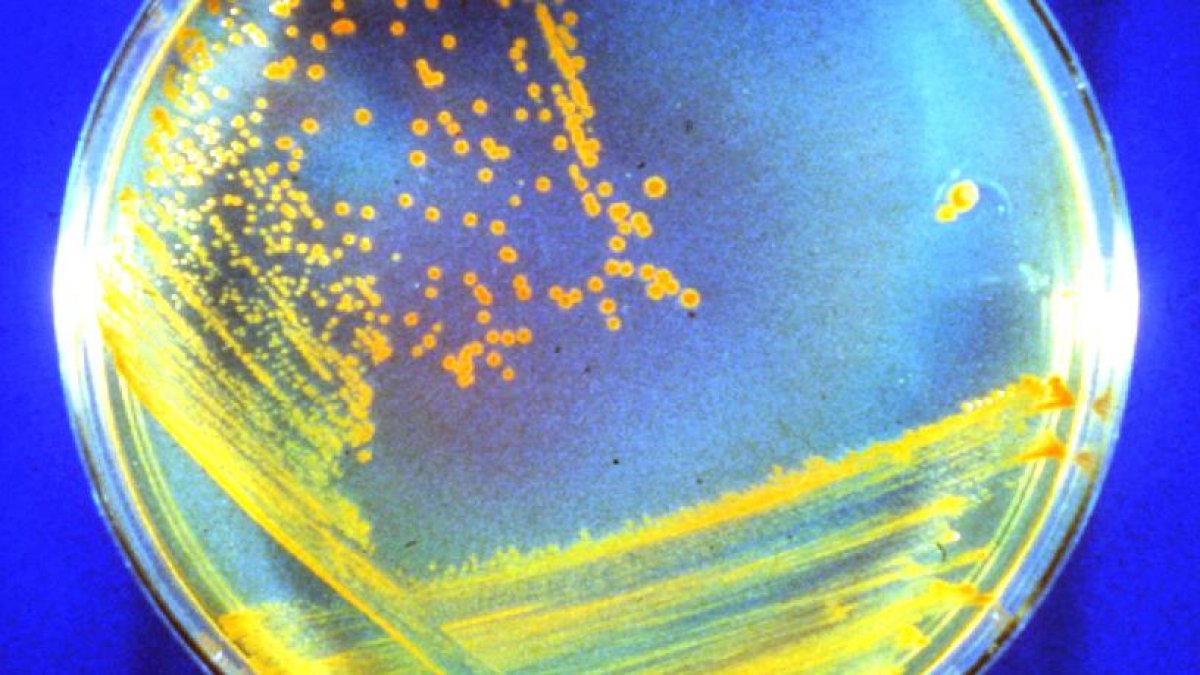
El Deinococcus radiodurans (bautizado como

Antiguas bacterias de Marte podrían estar latentes en las capas profundas
Científicos hallan un microbio robusto llamado Deinococcus radiodurans, que puede sobrevivir a las duras condiciones de Marte
El Deinococcus radiodurans (bautizado como "Conan la Bacteria") está especialmente indicada para sobrevivir al duro entorno de Marte.
Las antiguas bacterias de Marte podrían sobrevivir cerca de la superficie del planeta mucho más tiempo del que se creía y, si además están enterradas y -con ello- protegidas de la radiación cósmica y solar, podrían sobrevivir todavía más.
Este hallazgo -publicado hoy en la revista Astrobiology- plantea la posibilidad de que, si alguna vez hubo vida en Marte, sus restos biológicos podrían ser recuperados por las misiones ExoMars (ESA) y Mars Life Explorer (NASA), enviados a la Tierra para su estudio, y contaminar nuestro planeta.
Pero las implicaciones de la investigación van más allá: si las cepas bacterianas son capaces de sobrevivir en un entorno tan duro como el de Marte, los astronautas y futuros turistas espaciales también podrían contaminar el planeta rojo con sus bacterias.
El artículo, liderado por la Universidad de Northwestern (Estados Unidos) y cuyos detalles se publican hoy en la revista Astrobiology, advierte de que la contaminación terrestre en Marte podría durar miles de años.
Las condiciones de Marte son extremas: El planeta es árido, muy frío (está a una media -63 grados Celsius en latitudes medias) y está constantemente bombardeado por una intensa radiación cósmica y solar.
Para comprobar si la vida podría sobrevivir en estas condiciones, los investigadores determinaron los límites de supervivencia de la vida microbiana a la radiación y después sometieron a seis tipos de bacterias y hongos terrestres a unas condiciones similares.
Así, observaron que algunos microorganismos terrestres podrían sobrevivir en Marte durante escalas de tiempo geológicas de cientos de millones de años.
Los investigadores descubrieron que un microbio robusto, el Deinococcus radiodurans (apodado "Conan la Bacteria"), es especialmente adecuado para sobrevivir a las duras condiciones de Marte.
En los experimentos, Conan sobrevivió a cantidades astronómicas de radiación en un entorno gélido y árido.
En estudios anteriores, los investigadores habían descubierto que la bacteria Conan, cuando está suspendida en líquido, puede sobrevivir a 25.000 unidades de radiación (o "grises"), el equivalente a unos 1,2 millones de años justo debajo de la superficie de Marte.
El nuevo estudio descubrió que cuando la bacteria se seca, se congela y se entierra profundamente -lo que sería típico de un entorno marciano- podría soportar 140.000 grises de radiación, una dosis 28.000 veces superior a la que mataría a un ser humano.
Así, aunque Conan sólo podría sobrevivir durante unas horas en la superficie expuesta a la luz ultravioleta, podría sobrevivir mucho más tiempo a la sombra o bajo la superficie de Marte.
Enterrada a 10 centímetros por debajo de la superficie marciana, el periodo de supervivencia de Conan la bacteria aumenta a 1,5 millones de años, y enterrada a 10 metros de profundidad, la bacteria de color calabaza podría sobrevivir la friolera de 280 millones de años, apunta el estudio.
Esto significa que si un microbio similar a la bacteria Conan evolucionó durante una época en la que el agua fluyó por última vez en Marte, entonces sus restos vivientes podrían estar todavía latentes en el subsuelo profundo, concluyen los investigadores.